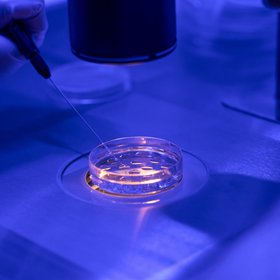
Китайские ученые вырастили бьющееся сердце с клетками человека в эмбрионе свиньи
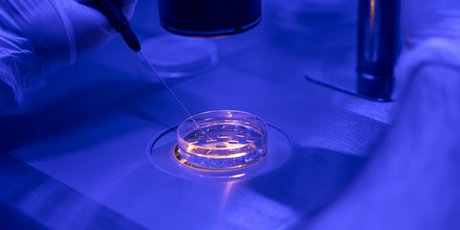
Китайские ученые вырастили бьющееся сердце с клетками человека в эмбрионе свиньи

В Великобритании ученые помогли парам с генетическими заболеваниями родить здоровых детей. Для этого они использовали технология сочетания ДНК трех людей. В результате родились 8 здоровых детей. Об этом сообщает MIT Technology Review.
Матери детей являются носительницами генов, которые вызывают митохондриальные заболевания. У них был высокий риск передать эти болезни своим детям. Чтобы этого не произошло, ученые использовали донорскую митохондриальную ДНК здорового человека.
Для этого ученые оплодотворили яйцеклетку женщин спермой их мужей и партнеров. Затем они вынули оплодотворенное ядро, содержащее ДНК, и переместили его в оплодотворенные донорские яйцеклетки, из которых предварительно удалили ядро.
В результате эмбрионы содержат ДНК своих родителей и небольшую долю митохондриальной ДНК донора, находящуюся в цитоплазме эмбрионов.
«Концепция [донорства митохондрий] вызвала много комментариев, а иногда и опасений и тревог. Команда из Ньюкасла продемонстрировала, что её можно использовать клинически эффективно и этически приемлемым способом для предотвращения болезней и страданий», — заявил консультант по репродуктивной медицине в клинике Медицинского колледжа Лондона Стюарт Лавери.